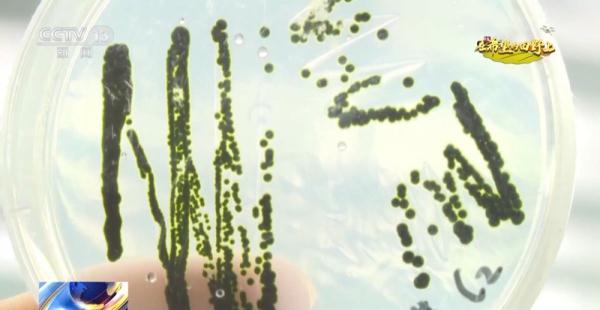
从寸草不生到鱼虾满满 盐碱地里养出大海虾

盐碱地不仅是后备耕地资源,它还有着另一个我们并不熟悉的利用方式,就是水产养殖。通过这种方式,很多内陆地区养殖出来的水产品也有了和海鲜一样的口味。眼下,河南省开封市兰考县的盐碱地里,鱼虾到了收获时节。
总台记者 张芷旖:一杯盐碱地的水,它的盐度是两克盐每升,喝起来有点咸,并不适合人体长期饮用。但它却实现了在河南养海鲜的梦想。

在河南兰考县的一处海产养殖基地,到了九月下旬,这里的南美白对虾迎来了丰收。盐碱地里怎么养海鲜?

想要在内陆养好海鲜,水质是一个技术难题,它的秘诀就藏在池塘里。仔细观察会发现,这里的池塘呈现出碧绿色,其中富含一种特殊的藻类——小球藻。小球藻,它可是球小本领大,不仅可以释放氧气,还可以净化水质,是一种有益藻类。当初科研团队为了找到它,花了两年的时间,接下来就让我们一起去小球藻的实验室里看一看。

河南大学作物逆境适应与改良国家重点实验室教授 王强:我们当时从野外分离到300多株不同的水样,几千株不同的藻种,最终筛选获得这么一株。它的主要特点是能够有效地利用氨氮。大多数养殖水产它排出来的粪便主要以氨态氮为主,如果氨氮超标,那么就会造成养殖水产中毒。这个小球藻除了高效地利用硝态氮以外,它能够适应并且高效利用氨态氮。
这种耐盐、耐碱、又能吸收氨态氮的小球藻,就像一个天然高效的转化器,把鱼虾粪便转化为自身的营养,保持水体清洁,形成以水养藻、以藻养虾的新型循环系统。

河南大学作物逆境适应与改良国家重点实验室教授 王强:目前,我们已经形成一个成套的、可复制、可推广的一个技术,我们希望把这个技术在河南省的盐碱地以及滩涂地全面推广,让河南的老百姓或者中原地区的老百姓能够吃到自己养殖的海鲜。
宁夏:渔农循环生态养殖 助力盐碱地效益提升
在宁夏,盐碱地不仅可以大力发展渔业,养殖本身也在促进盐碱地的改良。他们是怎么做的?
渔业是宁夏的优势特色产业之一,全区渔业养殖面积有50万亩,而其中就有相当一部分的养殖基地建在盐碱地里,利用盐碱水养殖。

宁夏水产技术推广站站长 李斌:目前,我们宁夏在盐碱地上,开展渔农综合利用的面积是23.18万亩。

在盐碱地里搞养殖,无论是海水苗种还是淡水苗种,都要在本地经过多次驯化,最终让它们适应宁夏的盐碱水质环境。养殖户杨新立有80多亩南美白对虾,前三年,因为驯化这些海水虾苗不成功,赔了不少。进入第四年,在水产技术人员的指导下,他终于扭亏为盈。

银川市兴庆区红柳林农场 杨新立:前三年的产量不行,从第四年开始,连续这三年,产量从400斤、500斤、550斤,今年有望能突破600斤。

宁夏水产研究所研究员 李力:盐碱水的水质跟海水还是有差别的,宁夏这个硫酸盐形成的盐碱水,它缺钾离子,(虾)在脱壳期间缺钙离子,这样进行微量的调整、补充,再对水质进行调控。
那么,盐碱地里水产的口感怎么样,专家们曾经就盐碱水养殖的南美白对虾分别和海水虾以及淡水虾作了比对。

中国水产科学研究院东海水产研究所水产养殖技术研究室主任 来琦芳:发现基本上用盐碱水养殖这些品种的话,和海水养殖的虾的口感度和海水的都比较接近。

盐碱地里养殖水产,不仅让当地人增加了收入,在这个过程中,也在不断改良盐碱地。在宁夏石嘴山市的富民村,养殖企业的员工们正在捕捞鲈鱼。负责人告诉记者,养殖池里的水是从水稻田排出的盐碱水,自打他们实施以鱼降盐治碱综合利用项目以来,光秃秃的盐碱田也种出了水稻。

宁夏泰嘉渔业有限公司总经理 王永利:在四年前,就是寸草不生,连草都没有。籽粒还是比较饱满,今年基本上就达到(正常地块)一半(产量)。

王永利说,通过淡水灌溉会将盐碱田里的盐和碱排出地块,排出的盐碱水则过一道道排水沟循环到蓄水池,最后被输送到养殖池里养鱼,养鱼产生的排泄物经过过滤后回输到水稻田,这样的渔农综合利用模式让盐碱地不断变好。
中国水产科学研究院东海水产研究所水产养殖技术研究室主任 来琦芳:通过这几年的监测发现,土壤的盐度在(通过)水产养殖以后,盐度从千分之二十一,现在已经(降)到了千分之二点几,基本可以开展水稻种植,所以现在在宁夏成了一个以鱼降盐治碱渔业综合利用模式。
山东盐碱地变形记:从寸草不生到鱼虾满满
这些天,山东滨州市沾化区的几十万亩盐田虾喜获丰收。这里的土地因为盐碱程度高、面积占比大,曾经成为制约当地经济发展的一大困难。那么从寸草不生到鱼虾满满,是如何焕发出新生机的?
俗话说,靠山吃山、靠水吃水。在滨州市沾化区,由于大部分都是盐碱地,当地经过考察研究,决定把海水抽到盐碱地里,搞对虾养殖。
然而事情并不简单,由于土地含盐碱量高,抽上来的海水,过不了多久,盐碱浓度就会升高很多,让普通的对虾品种很难存活。

中国科学院海洋研究所研究员 于洋:超出了正常对虾的盐度耐受极限,这部分水面如果想要利用,就要培育适合更加耐高盐的对虾新品种。

为破解这个难题,当地政府积极联络对接科研院所,先后自主研制出了抵抗能力更强的对虾品种,可以适合在盐浓度在55‰,甚至更高盐度的环境中进行养殖。
起初,尽管有了合适的品种,但因为当地养殖户经验不足,养虾的效益并不好,虾苗的成活率还不到20%。为此,当地积极引进龙头养殖企业示范带动,为养殖户提供先进的养殖技术,经过几年的发展,一亩盐碱地的养虾收成,逐渐赶上良田产值。

滨州市沾化区某水产公司副总经理 陈锚:原来这里是一贫如洗,(土地)产值为0。我们养虾现在增加800到1000块钱的(收入),这个意义我觉得完全不一样。

可是,新问题又来了,对虾养殖尾水的排放又成了一个难题。乱排放会造成污染,但不排放,来年养的虾就很容易生病。既要发展,又要兼顾环保。为此当地创新尝试了盐碱地“梯级”养殖模式。先用千分之四十五到千分之六十盐度的海水养对虾。养殖一段时间后,当盐浓度超过千分之六十,就排放到另外的池子里用来养殖丰年虫。

滨州市沾化区某水产公司副总经理陈锚告诉记者,在这种环境里,没有任何生物能和丰年虫竞争,它长得非常快,同时因为蛋白质含量高,所以在养殖后将成为对虾的重要食物来源。这样的循环利用,做到了尾水零排放。

滨州市沾化区海洋发展和渔业局党组书记 局长 张玉忠:盐田虾的梯级养殖,不仅仅是让我们的养殖户大大地实现了增收,更重要的是保护了生态环境。
眼下,沾化区共有盐田虾养殖面积30多万亩,2022年产量3.81万吨,仅仅对虾就实现产值16亿元,有效带动了当地百姓增收。


点击右上角![]() 微信好友
微信好友
 朋友圈
朋友圈

点击浏览器下方“ ”分享微信好友Safari浏览器请点击“
”分享微信好友Safari浏览器请点击“ ”按钮
”按钮

点击右上角 QQ
QQ

点击浏览器下方“ ”分享QQ好友Safari浏览器请点击“
”分享QQ好友Safari浏览器请点击“ ”按钮
”按钮
